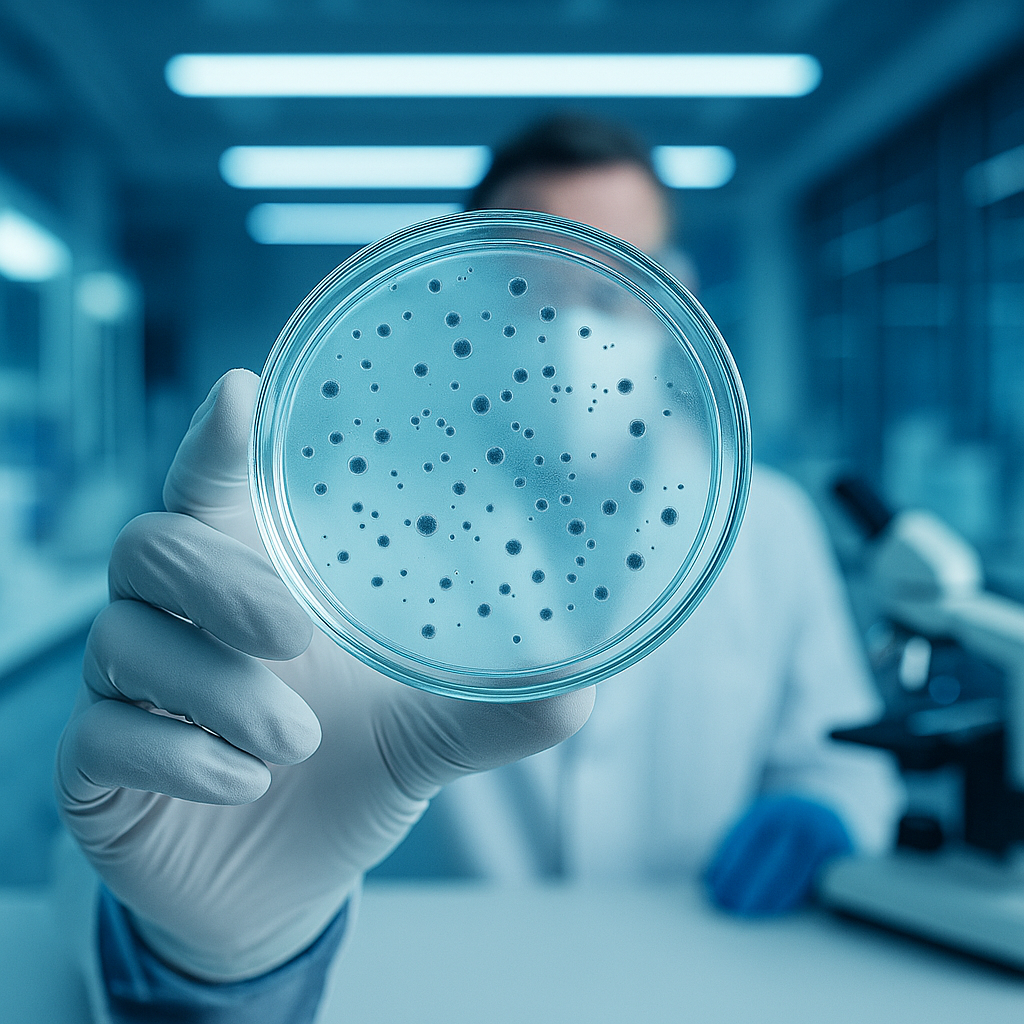

Your body is unique. It's care should be too
Uncover the hidden imbalances defining your health. This advanced test scientifically decodes the exact probiotic strains missing from your microbiome. By analysing microbial markers with advanced RNA sequencing technology, it reveals how deficiencies impact your digestion, immunity, skin, metabolism, and even mood.
With these insights, you can tailor nutrition, personalise supplements and lifestyle modifications to empower you to restore harmony in your body and achieve desired health goals.
Take This Test to Optimize
See What Test Report Looks Like
Download a sample report to explore the comprehensive insights on probiotic strain wise deficiency levels, connection of different strains with desired health goals and personalized recommendations on which strains to replenish.

Why This Test Matters
Probiotics are the ‘good bacteria’ that power digestion, immunity, metabolism, mood, hair, skin & reduce risk lifestyle disorders. Deficiency of these strains can lead to IBS, food intolerances, skin issues, fatigue, and more. This test helps you identify exactly which strains your body is missing and helps your with actionable insights to supercharge your overall wellbeing & longetivity.
Actionable Insights to Boost Your Wellbeing

Identify Deficiencies
Trillions of bacteria in your body, but not all of them work in your favor. This test identifies exactly which beneficial probiotic strains are absent or severely deficient. Knowing what’s missing helps us avoid guesswork and focus only on the strains your body truly needs.
Impact on Health
Deficiencies in probiotics don’t just cause indigestion, they ripple through your entire body. Missing strains can weaken immunity, disrupt nutrient absorption, trigger food intolerances, and even affect mental health. From low energy and poor skin health to mood swings and brain fog, the test shows how your deficiencies may be holding you back.

Craft Supplements that are Right for You
Most over-the-counter probiotic supplements are generic, with limited strains that may not match your needs. This test compares what you’re currently taking against what your body actually lacks. You’ll learn whether your supplement is truly effective, or if it’s missing the strains that matter most for your health.

Personalize your Nutrition
Based on your results, you’ll receive a personalized roadmap to restore balance. This includes targeted probiotic recommendations, foods to add (or avoid), and lifestyle adjustments tailored to your microbiome. Unlike one-size-fits-all advice, this plan is built from your unique data,empowering you to reverse symptoms, strengthen resilience, and achieve lasting health
Frequently Asked Questions

What is the Probiotic Deficiency Test
It’s a gut test that identifies missing or deficient probiotic strains.
Is this Test right for me
Take this test to uncover the impact of probiotic deficiency on your digestive health, immunity, skin radiance, or nutrient gaps. Anyone with consuming probiotics or optimizing their body's daily nourishment shouldn't skip this test.
What happens after I get my Test Report
You’ll have a 30-min consult with a Gut Expert to explain results & discuss next steps to help your get personalized recommendations towards overall wellbeing
Any restrictions or special instructions before taking this test
Shouldn't have consumed any Antibiotics in the last 7 days
How long does it take to get results
Reports are generated in 14–21 days after sample collection.
How is the sample collected
It’s a simple at-home stool test with free doorstep pickup. Just WhatsApp/call us once your sealed sample is ready.
Are your labs certified
Yes, labs are NABL & ISO certified
Check if Your Body is Missing Critical Probiotics
Answer 10 quick questions to find your probiotic balance score.
Probiotic Deficiency Risk
Based on your responses, our predictive model indicates the probability of probiotic imbalance. These results are indicative and should be confirmed with a diagnostic test for clinical decisions.














